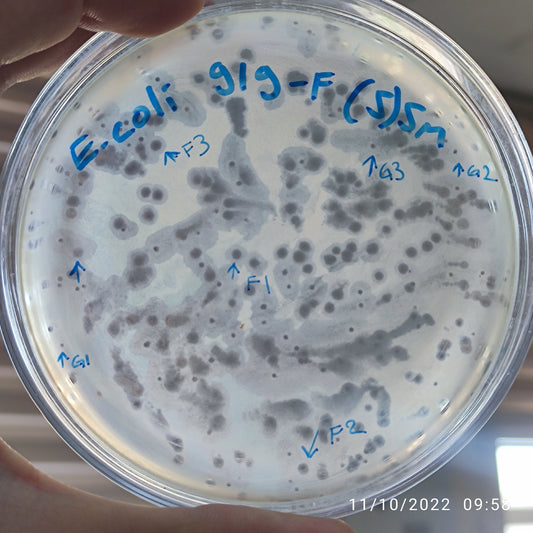
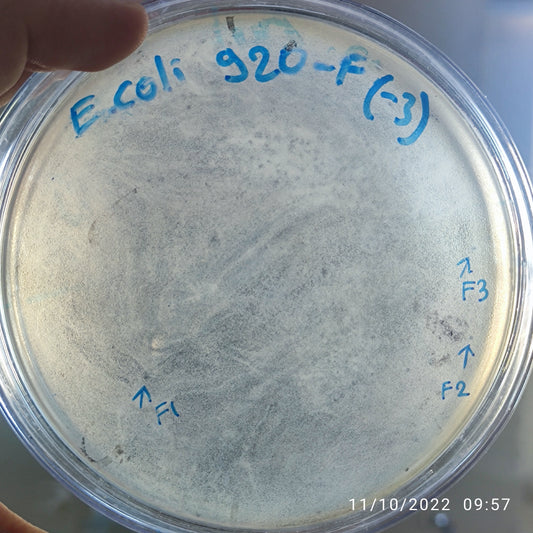
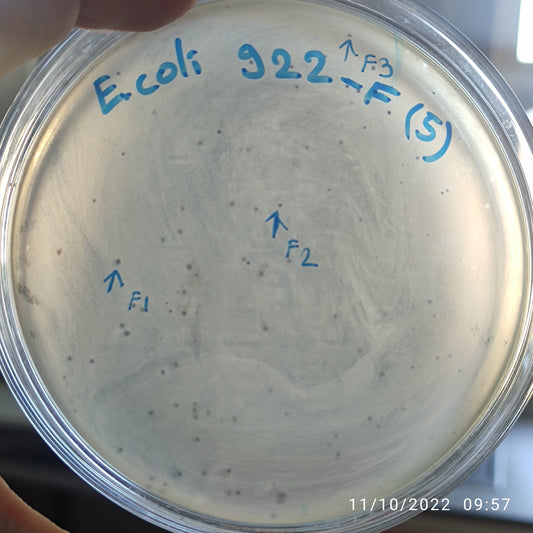
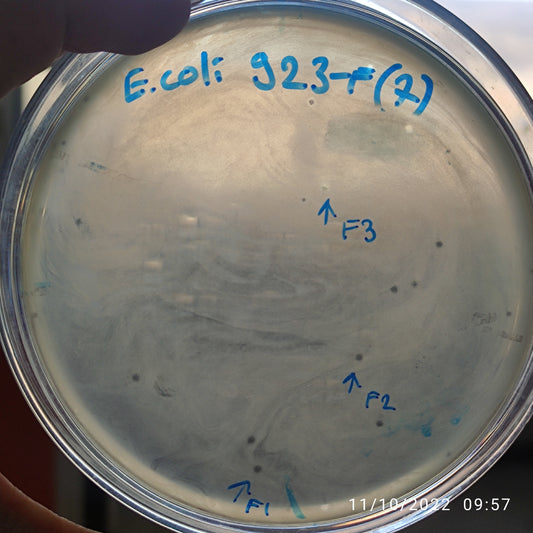
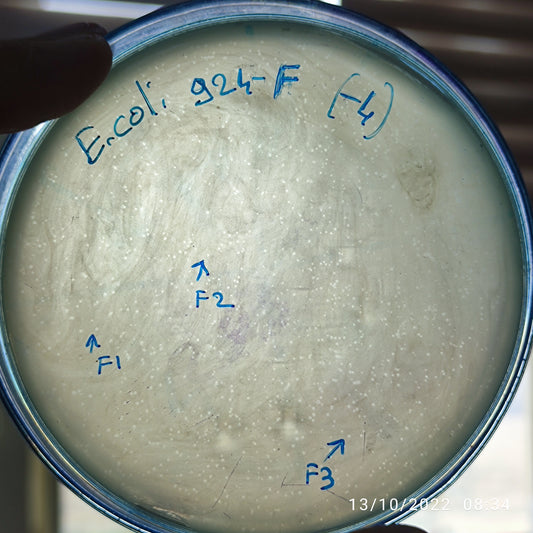
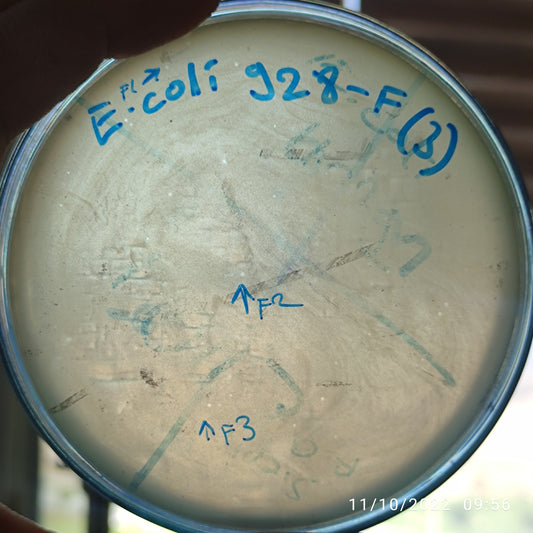
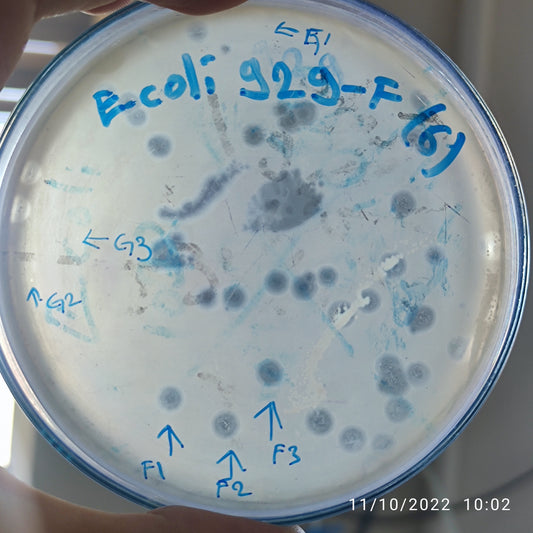

-
Escherichia coli bacteriophage 100918G
Regular price $500.00 USDRegular priceUnit price per -
Escherichia coli bacteriophage 100919F
Regular price $750.00 USDRegular priceUnit price per -
Escherichia coli bacteriophage 100919G
Regular price $750.00 USDRegular priceUnit price per -
Escherichia coli bacteriophage 100920F
Regular price $500.00 USDRegular priceUnit price per -
Escherichia coli bacteriophage 100921F
Regular price $500.00 USDRegular priceUnit price per -
Escherichia coli bacteriophage 100922F
Regular price $750.00 USDRegular priceUnit price per -
Escherichia coli bacteriophage 100923F
Regular price $650.00 USDRegular priceUnit price per -
Escherichia coli bacteriophage 100924F
Regular price $500.00 USDRegular priceUnit price per -
Escherichia coli bacteriophage 100925F
Regular price $500.00 USDRegular priceUnit price per -
Escherichia coli bacteriophage 100925G
Regular price $500.00 USDRegular priceUnit price per -
Escherichia coli bacteriophage 100928F
Regular price $500.00 USDRegular priceUnit price per -
Escherichia coli bacteriophage 100929F
Regular price $750.00 USDRegular priceUnit price per -
Escherichia coli bacteriophage 100929G
Regular price $500.00 USDRegular priceUnit price per -
Escherichia coli bacteriophage 100930F
Regular price $750.00 USDRegular priceUnit price per -
Escherichia coli bacteriophage 100930G
Regular price $500.00 USDRegular priceUnit price per -
Escherichia coli bacteriophage 100931F
Regular price $500.00 USDRegular priceUnit price per